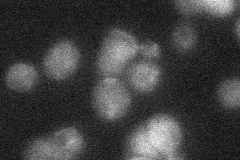
YDL199C
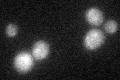
YDL199C

View description
Putative transporter, member of the sugar porter family
Localization:
Intensity:
Fold change:
Significance:
-
C’ GFP library in SD

below threshold18.5 -
N' NOP1pr-GFP in SD

vacuole membrane48.6648 -
N' TEF2pr-mCherry in SD

vacuole membrane64.8712 -
N' NATIVEpr-GFP in SD
below threshold21.3333 -
N' TEF2pr-VC and Cyto-VN in SD

punctate,vacuole membrane41.7241 -
C’ GFP library in SD+DTT
cytosol16.610.89No -
C’ GFP library in SD+H2O2

cytosol16.730.9No -
C’ GFP library in Starvation Media

cytosol33.421.8No -
C’ GFP library on the background of Pup2-DaMP

N/A -
C’ GFP library on the background of CCT mutant

N/A0N/AYes
